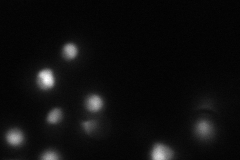

View description
Single stranded RNA binding protein; acidic ribonucleoprotein; required for termination of non-poly(A) transcripts and efficient splicing; interacts with Nrd1p
Localization:
Intensity:
Fold change:
Significance:
-
C’ GFP library in SD

punctate33.22 -
N' NOP1pr-GFP in SD

nucleus67.7791 -
N' TEF2pr-mCherry in SD
nucleus38.9591 -
N' NATIVEpr-GFP in SD

nucleus73.8666 -
N' TEF2pr-VC and Cyto-VN in SD

#N/A0 -
C’ GFP library in SD+DTT

punctate39.261.18No -
C’ GFP library in SD+H2O2

punctate36.661.1No -
C’ GFP library in Starvation Media

punctate52.841.59Yes -
C’ GFP library on the background of Pup2-DaMP

punctate -
C’ GFP library on the background of CCT mutant

punctate51.22431.54166Yes
